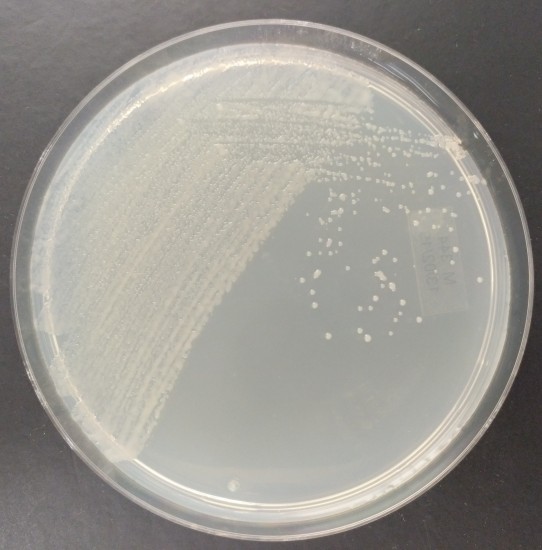
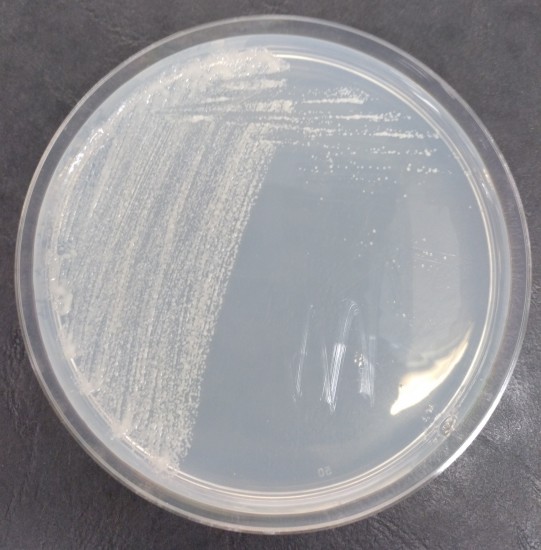
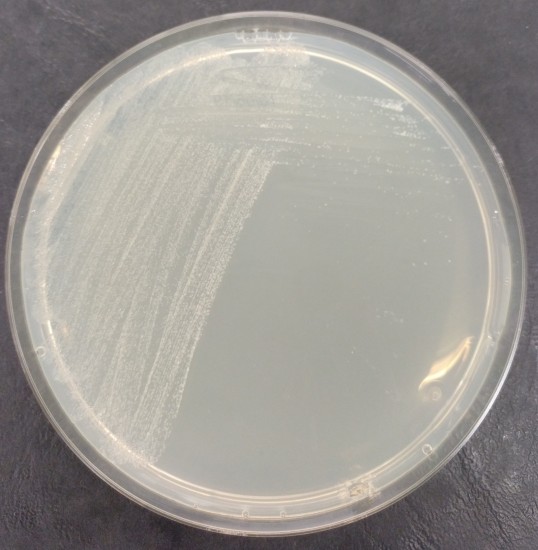

| Name |
Bradyrhizobium lupini Peix et al. 2015 |
|
| Strain designation | USDA 3051 |
|
| Other collections | LMG 28514; USDA 3051 |
|
| Access in situ (sampling data) | Source: Nodules of Lupinus angustifolius Country of access: United States Locality, State of access: Georgia Date of access: Before 13-04-2009 |
|
| Isolation data | Isolated by: Erdman, L. |
|
| History | CECT, 2014 < E. Velázquez, Univ. Salamanca, Spain, 2009 < USDA < L.W. Erdman |
|
| Growth conditions | Liquid media: 209 Solid media: 344 Growth temperature (in °C): 26 Incubation time: 72h Atmospheric needs: aerobic Cultivation conditions for CECT strains |
|
| Restrictions | Risk group: 1 CECT MTA |
|
| Genetic data | G+C mol%: 65.9 mol% 16S rRNA sequence: KM114861 Other genes sequences: recA, glnII and nodC: KM114866, KM114862 and KM114864 |
|
| Delivery | | Freeze-dried culture | | Acticult® 3R | | Active culture rate A | | Genomic DNA |
Tarifas de presentaciones |
|
 Temperature: 26.0°C CECT Culture medium 209: Yeast Mannitol Agar (YMA) (7days)  Temperature: 26.0°C CECT Culture medium 312: TY MEDIUM (7days) Temperature: 26.0°C CECT Culture medium 344: Rhizobium Agar USAL (MICROKIT DMT232) (7days) |
| La CECT sigue estándares de calidad para garantizar la viabilidad, pureza y autenticidad de las cepas que conserva. La información mostrada en esta ficha procede de diversas fuentes. Algunas de las propiedades no han sido necesariamente contrastadas por la CECT |